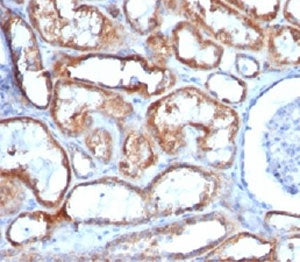
Mitochondrial Marker Antibody

NSJ Bioreagents
SKU:V2352IHC-7ML
Mitochondrial Marker Antibody
Mitochondrial Marker Antibody
Couldn't load pickup availability
Clone 113-1 antibody recognizes a 60kDa antigen that is a mitochondrial marker in human cells. Immunostaining produces a spaghetti-like pattern in normal and malignant cells. This mitochondrial marker antibody is an excellent marker for human cells in xenographic model research. Abundant granular eosinophilic cytoplasm is a common feature of renal oncocytoma, chromophobe renal cell carcinoma, eosinophilic variant of papillary renal cell carcinoma, and the granular variant of clear cell renal cell carcinoma (RCC). The chief reason for their distinction from one another is the difference in their biologic behavior. However, precise characterization may be difficult in some cases because of overlapping morphologic features. Immunostaining pattern with this mitochondrial marker antibody has been reported as a useful discriminatory adjunct in the complex differential diagnosis of granular renal cell tumors. Salivary gland tumors usually show great variability both in their morphopathology as well as their clinical behavior. One study highlights the usefulness of this mitochondrial marker antibody to facilitate the classification of salivary tumors, an aspect that may sometimes have not only diagnostic implications, but also prognostic.
Share